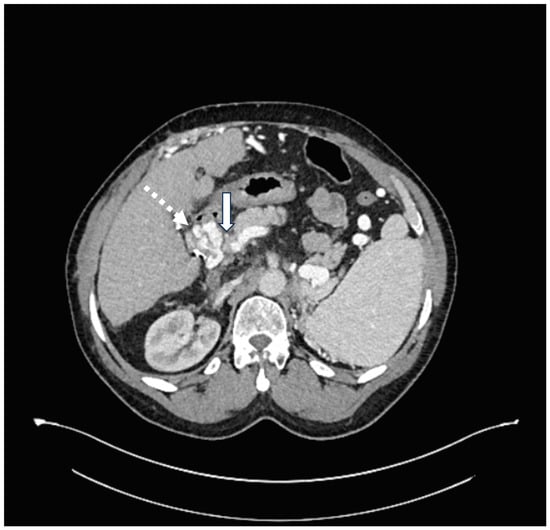

Abstract
Hepatic arterio-portal venous fistula (HAPVF) is a rare, abnormal connection between the hepatic artery and portal vein. HAPVFs are usually caused by trauma or hepatobiliary instrumentation. Fistulas can expand and produce symptoms of severe portal hypertension. The decision to embolize should be based on fistula location, size, and symptoms. We report a case of HAPVF in a liver transplant recipient presenting with worsening ascites and variceal hemorrhage after several prior liver biopsies. Given the extensive nature of the fistula and hepatic decompensation, the HAPVF was successfully embolized, resulting in clinical improvement and obviating the need for re-transplantation.
1. Introduction
Hepatic arterio-portal venous fistula (HAPVF) is a rare, abnormal connection between the hepatic artery and portal vein. HAPVFs are commonly traumatic in origin, either from a mechanical or iatrogenic injury. Iatrogenic HAPVF is most commonly reported following liver biopsies but can also occur following liver transplantation and transhepatic biliary interventions [1,2,3]. Other less common etiologies include rupture of arterial aneurysms, hepatic neoplasms, congenital syndromes, or cirrhosis [2,4,5,6].
In HAPVFs, hepatic arterial blood flow is redirected to the portal vein and can lead to portal hypertension. The timeline for HAPVF development may be rapid or gradual. The latency period between the cause and the diagnosis of the fistula is typically several months but can range from a few hours to decades [7]. The progression and detection of HAPVFs depend on the location and size. Large and extrahepatic/central fistulas tend to increase in size and can progress to produce symptoms of portal hypertension [7,8]. Small, peripheral intrahepatic fistulas usually resolve spontaneously [7,9]. When detected, the decision to treat depends on the location, size, and presence of symptoms [10].
2. Case Presentation
A 65-year-old man with a history of orthotopic liver transplant 5 years prior and recurrent hepatitis C-related cirrhosis had an incidental finding of HAPVF after presenting with abdominal pain and distention due to large volume ascites. Abdominal computed tomography with intravenous contrast described a tortuous hepatic artery with the early opacification of the main portal vein on arterial phase imaging (Figure 1), suggestive of HAPVF. The left portal vein was thought to be thrombosed due to its absence on the scan. Numerous varices and massive ascites were also noted.

Figure 1.
Intrahepatic communication between hepatic artery and portal vein. (A) Contrast-enhanced axial computed tomography of the abdomen demonstrating early opacification of the dilated portal vein on arterial phase (arrow). (B) Contrast-enhanced coronal computed tomography of the abdomen demonstrating early opacification of the dilated portal vein on arterial phase (arrow). (C) Contrast-enhanced magnetic resonance imaging of the abdomen demonstrating early opacification of the portal vein on arterial phase (arrow).
Over the preceding five years, he had many post-operative complications, including the development of fibrosing cholestatic hepatitis C, despite successful eventual treatment with direct-acting anti-viral therapy. Five years after transplant, he suddenly suffered several decompensating events, including recurrent ascites requiring diuresis and esophageal variceal bleeding requiring banding. Other post-transplant complications included biliary stricture requiring endoscopic retrograde cholangiopancreatography (ERCP) with stent placement 4 years prior to presentation. He also had multiple liver biopsies in the months and years prior to presentation, including a percutaneous liver biopsy four and a half years prior, and two transjugular biopsies four years prior to presentation, within a month of each other. Those transjugular biopsies notably reported an interval increase in portosystemic gradient from 8 to 16 mmHg. On histopathology, the liver biopsies performed 4 years prior (1 year after transplant) had fibrosis scores of 2/6 and 3/4. Lastly, two months prior to presentation, he had another transjugular liver biopsy performed for elevated liver enzymes (not for symptoms of decompensation, which had not occurred at that point), which found a portosystemic gradient of 15 mmHg and micronodular cirrhosis. Despite having a similar portosystemic gradient as 4 years prior, the patient noted that his ascites developed after the last biopsy, and his only post-transplant variceal hemorrhage occurred 3 weeks after this biopsy. No HAPVF had been seen on several scans performed in the years since his first two transjugular liver biopsies and the third one.
Given the extensive nature of the HAPVF and his hepatic decompensation, the decision was made to treat the fistula with transcatheter embolization. His pre-operative lab work included a creatinine of 1.6 mg/dL, total bilirubin 1.48 mg/dL, platelets 51,000, and INR 1.35. Celiac arteriography revealed a dilated and extremely long and tortuous common and proper hepatic artery (Figure 2A). Hepatic arteriograms demonstrated a short-segment fistula between the right hepatic artery and the portal vein (Figure 2B,C). Close and central to the fistula were two significant branches of the right hepatic artery. Attempts were made to deploy a vascular plug into the fistula without success because the delivery sheath could not track along the tortuous hepatic artery. The initial placement of detachable coils resulted in unconstrained extension into the main portal vein, requiring their removal before deployment. Finally, detachable coils were deployed into the short-segment fistula (one Concerto 2 mm and one Concerto 8 mm coil). A post-embolization arteriogram showed occlusion of the HAPVF without injury to the two adjacent normal right hepatic arteries (Figure 2D). His bilirubin decreased from 1.48 to 1.02 mg/dL. Post-procedure MRI found successful closure of the HAPVF with patent hepatic arteries and portal vein without early enhancement, but rather with occlusion of the main, left, and right portal veins. There were periportal collaterals suggesting cavernous transformation. We presume that the hepatic artery had been providing retrograde flow into the portal system, which subsequently thrombosed after fistula closure. The splenic vein and superior mesenteric vein remained patent. A CT scan with contrast performed 4 years after embolization shows persisting portal vein thrombosis and the collateralization of portal venous inflow (Figure 3).

Figure 2.
Management of hepatic arterio-portal venous fistula. (A): Celiac axis arteriogram shows hypertrophied and tortuous common/proper hepatic arteries (arrowhead) and bulbous portal vein (arrow). (B): Right hepatic artery arteriogram shows tortuous hepatic arteries with short-segment hepatic artery fistula (dashed arrow) with immediate opacification of the portal vein (arrow). (C): Right hepatic artery arteriogram shows short-segment hepatic artery fistula (dashed arrow) with immediate opacification of the portal vein (arrow). (D): Right hepatic artery arteriogram status post coil embolization of short-segment fistula shows two adjacent right hepatic arteries that remain patent (arrow, arrowhead). Portal vein is no longer appreciated.
Figure 3.
Post-procedure CT scan of abdomen performed 4 years after HAPVF embolization. Solid arrow indicates portal vein thrombosis. Dashed arrow indicates collateral blood vessel at hepatic hilum.
The patient has had over 4.5 years of follow-up since the embolization and required only one paracentesis for ascites three weeks after the procedure. He was continued on low-dose diuretics with control of the ascites. He has had several endoscopies with variceal banding, but no further bleeding. He was referred for liver re-transplant evaluation, but given his improved symptoms and the high risk of a second liver transplant, the embolization of the fistula served as definitive therapy. Finally, 3 years following HAPVF embolization, the patient underwent another percutaneous liver biopsy due to elevated liver enzymes and bilirubin, which showed features of chronic rejection, but only stage 2 fibrosis.
3. Discussion
Since HAPVFs can go undetected for months or years, there are several iatrogenic injuries that may have caused this patient’s HAPVF. These include the initial liver transplantation five years prior, percutaneous liver biopsy four and a half years prior, two transjugular biopsies four years prior, and the most recent transjugular biopsy two months prior to the detection of the fistula. Another less likely etiology is the ERCP four years prior. ERCP with biliary stenting can cause hepatic artery pseudoaneurysms, which can rupture and develop into an AVF [11]. Given the time to the development of sequela of portal hypertension (massive ascites and varices) and the portosystemic gradient increasing between the two transjugular liver biopsies performed 4 years prior, one possible etiology is the first transjugular liver biopsy. However, given the temporal relation of ascites and variceal bleeding onset shortly following his third transjugular liver biopsy (despite the HVPG already being 15 mmHg at that point, similar to the value of 16 mmHg found 4 years prior), this biopsy could have been the precipitant for the fistula, which would have worsened his pre-existing portal hypertension. Although gel foam tract embolization is sometimes used to prevent bleeding complications following liver biopsy, no specific device or technique exists to prevent the rare complication of HAPVF formation, especially as most percutaneous or transjugular biopsies of the liver are performed randomly (following ultrasound confirmation of an acceptable tract, in the case of the percutaneous route). The avoidance of large vascular structures in the expected path of the biopsy needle is standard of care but would not necessarily prevent the formation of HAPVF between small vessels.
Fortunately for the patient, fistula embolization resolved his clinical signs and symptoms of portal hypertension, and even appears to have improved his degree of hepatic fibrosis, as evidenced by the results of the percutaneous liver biopsy performed 3 years later. This could be due to favorable alterations in hepatic perfusion.
Small, peripheral, and intrahepatic fistulas that are found incidentally often close spontaneously, and thus can be observed and managed conservatively [12]. Large, central, and extrahepatic fistulas should be treated because they are unlikely to spontaneously close [13]. On the other hand, some investigators support treatment in every case to prevent portal hypertension [2]. In this case, the patient had a central, extrahepatic fistula with worsening symptoms of portal hypertension, warranting treatment. Endovascular treatment, i.e., transcatheter arterial embolization, is preferred over surgery given its high success rate and non-invasiveness [13]. Complications of HAPVF embolization can include hepatic infarction or portal vein thrombosis, which this patient already had (of the left portal vein), but which progressed to involve the main and right portal veins following the intervention [14]. There is no specific technique or device to prevent portal vein thrombosis following this procedure, and the initiation of prophylactic anticoagulation is neither standard of care, nor routinely performed. In contrast to the case described by Gandhi et al., fortunately, our patient was a candidate for fistula embolization; hence, re-transplant has been obviated [14]. The patient’s periportal collaterals and cavernous transformation of the portal vein suggest that hepatic perfusion will be adequate, and the liver disease is unlikely to progress.
4. Conclusions
Although rare, HAPVF should be considered in the differential diagnosis of patients with worsening portal hypertension with any history of liver instrumentation. In liver transplant recipients with HAPVF and significant clinical sequelae, embolization of the fistula may obviate the need for re-transplantation.
Author Contributions
Conceptualization, J.A.Y. and Z.L.; data curation, J.A.Y., C.C. and Z.L.; writing—original draft preparation, J.A.Y. and Z.L.; writing—review and editing, J.A.Y., C.C. and Z.L. All authors have read and agreed to the published version of the manuscript.
Funding
This case report received no external funding.
Institutional Review Board Statement
Ethical review and approval was not required for this study as per national legislation (Code of Federal Regulations Title 45: Public Welfare Part 46: Protection of Human Subjects—https://www.ncbi.nlm.nih.gov/books/NBK19891/#a2001171cddd00148) due to its nature as a retrospective case report which does not meet the definition of human subjects research.
Informed Consent Statement
Written informed consent has been obtained from the patient to publish this paper.
Data Availability Statement
The data presented in this study are available on request from the corresponding author.
Conflicts of Interest
The authors declare no conflict of interest.
Correction Statement
This article has been republished with a minor correction to the Institutional Review Board Statement. This change does not affect the scientific content of the article.
References
- Kumar, A.; Ahuja, C.K.; Vyas, S.; Kalra, N.; Khandelwal, N.; Chawla, Y.; Dhiman, R.K. Hepatic Arteriovenous Fistulae: Role of Interventional Radiology. Dig. Dis. Sci. 2012, 57, 2703–2712. [Google Scholar] [CrossRef] [PubMed]
- Lumsden, A.B.; Allen, R.C.; Sreeram, S.; Atta, H.; Salam, A. Hepatic arterioportal fistula. Am. Surg. 1993, 59, 722–726. [Google Scholar] [PubMed]
- Mieles, L.A.; Waldman, D.; Orloff, M.S. Arterioportal fistulae following segmental liver transplantation in a child. Pediatr. Transplant. 2002, 6, 419–422. [Google Scholar] [CrossRef] [PubMed]
- Fischer, M.A.; Marquez, H.P.; Gordic, S.; Leidner, B.; Klotz, E.; Aspelin, P.; Alkadhi, H.; Brismar, T.B. Arterio-portal shunts in the cirrhotic liver: Perfusion computed tomography for distinction of arterialized pseudolesions from hepatocellular carcinoma. Eur. Radiol. 2017, 27, 1074–1080. [Google Scholar] [CrossRef] [PubMed]
- Gallego, C.; Miralles, M.; Marín, C.; Muyor, P.; González, G.; García-Hidalgo, E. Congenital Hepatic Shunts. Radiographics 2004, 24, 755–772. [Google Scholar] [CrossRef] [PubMed]
- Luo, M.-Y.; Shan, H.; Jiang, Z.-B.; Li, L.-F.; Huang, H.-Q. Study on hepatocelluar carcinoma-associated hepatic arteriovenous shunt using multidetector CT. World J. Gastroenterol. 2003, 9, 2455–2459. [Google Scholar] [CrossRef] [PubMed]
- Strodel, W.E.; Eckhauser, F.E.; Lemmer, J.H.; Whitehouse, W.M.; Williams, D.M. Presentation and Perioperative Management of Arterioportal Fistulas. Arch. Surg. 1987, 122, 563–571. [Google Scholar] [CrossRef]
- Puri, Y.; Srinivasan, P.; Peddu, P.; Heaton, N. Case Report of Multiple Bilobar Hepatic Arterio-Portal Fistulas Post–Liver Transplantation Managed Conservatively. Transplant. Proc. 2018, 50, 920–924. [Google Scholar] [CrossRef]
- Okuda, K.; Musha, H.; Nakajima, Y.; Takayasu, K.; Suzuki, Y.; Morita, M.; Yamasaki, T. Frequency of intrahepatic arteriovenous fistula as a sequela to percutaneous needle puncture of the liver. Gastroenterology 1978, 74, 1204–1207. [Google Scholar] [CrossRef]
- Gabriel, S.; Maroney, T.P.; Ringe, B.H. Hepatic Artery–Portal Vein Fistula Formation After Percutaneous Liver Biopsy In a Living Liver Donor. Transplant. Proc. 2007, 39, 1707–1709. [Google Scholar] [CrossRef] [PubMed]
- Güneyli, S.; Gök, M.; Çınar, C.; Bozkaya, H.; Korkmaz, M.; Parıldar, M.; Oran, İ. Imaging findings and endovascular management of iatrogenic hepatic arterial injuries. Diagn. Interv. Radiol. 2015, 21, 494–497. [Google Scholar] [CrossRef] [PubMed]
- Pietri, J.; Remond, A.; Reix, T.; Abet, D.; Sevestre, H.; Sevestre, M.A. Arterioportal Fistulas: Twelve Cases. Ann. Vasc. Surg. 1990, 4, 533–539. [Google Scholar] [CrossRef] [PubMed]
- Hirakawa, M.; Nishie, A.; Asayama, Y.; Ishigami, K.; Ushijima, Y.; Fujita, N.; Honda, H. Clinical outcomes of symptomatic arterioportal fistulas after transcatheter arterial embolization. World J. Radiol. 2013, 5, 33–40. [Google Scholar] [CrossRef] [PubMed]
- Gandhi, S.P.; Patel, K.; Sutariya, V.; Modi, P. Portal Vein Thrombosis and Arterioportal Fistula in Post Liver Transplant Recipient: A Case Report. J. Clin. Diagn. Res. 2016, 10, Td13–Td15. [Google Scholar] [PubMed]
Disclaimer/Publisher’s Note: The statements, opinions and data contained in all publications are solely those of the individual author(s) and contributor(s) and not of MDPI and/or the editor(s). MDPI and/or the editor(s) disclaim responsibility for any injury to people or property resulting from any ideas, methods, instructions or products referred to in the content. |
© 2024 by the authors. Licensee MDPI, Basel, Switzerland. This article is an open access article distributed under the terms and conditions of the Creative Commons Attribution (CC BY) license (https://creativecommons.org/licenses/by/4.0/).